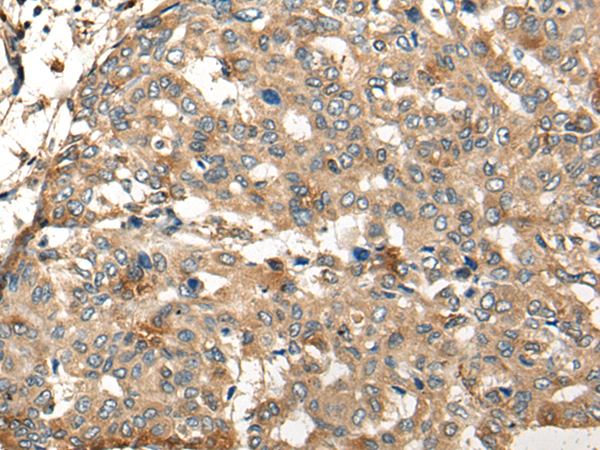

-
分类: 科研抗体货号: P06256别名: DMTase; NY-CO-41应用: WB,IHC反应种属: Human, Mouse
-
分类: 科研抗体货号: P06246别名: ZMIZ5应用: IHC反应种属: Human, Mouse, Rat
-
分类: 科研抗体货号: P06317别名: bA690P14.1应用: WB,IHC反应种属: Human, Mouse
-
分类: 科研抗体货号: P06245别名: ARI; HARI; HHARI; UBCH7BP应用: IHC反应种属: Human, Mouse
-
分类: 科研抗体货号: P06355别名: E2; E2B; BCATE2; BCKADE2; BCKAD-E2; BCOADC-E2应用: WB,IHC反应种属: Human, Mouse
-
分类: 科研抗体货号: P06316别名:应用: IHC反应种属: Human, Mouse
-
分类: 科研抗体货号: P06242别名: ADRA2; ADRAR; ZNF32; ADRA2R; ALPHA2AAR应用: WB,IHC反应种属: Human, Mouse, Rat
-
分类: 科研抗体货号: P06354别名: BAM32应用: WB,IHC反应种属: Human, Mouse
-
分类: 科研抗体货号: P06312别名: SCYA11应用: IHC反应种属: Human
-
分类: 科研抗体货号: P06238别名: HRMT1L6应用: WB,IHC反应种属: Human, Mouse

鄂公网安备42018502007531号
鄂公网安备42018502007531号

